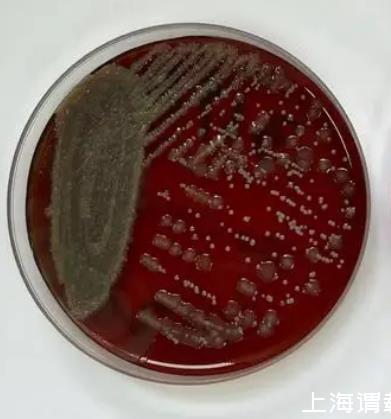

盐碱土是由多种自然环境因素和人为活动因素综合作用下形成的不同程度盐碱化土壤的统称。盐碱土壤不能为植物生长提供正常的养分条件,加上盐碱成分的生理毒害作用,严重影响植物的生长,从而造成了盐碱土有限的生态潜力。
目前,对我国盐碱土壤中微生物的研究多数集中在细菌和真菌群落。细菌是土壤微生物中数量最大、种类最多且功能多样的类群,其在土壤形成、凋落物分解和养分循环中均具有重要作用。在盐碱土中细菌同样分布广泛,发挥着重要作用。随着人们对盐碱土壤微生物的不断重视,国内已报道了很多关于我国不同地域盐碱土壤细菌分布及群落多样性的研究结果,发现不同地域盐碱土壤的细菌群落结构组成和优势类群均有差异。
在西北荒漠盐碱土地区,细菌群落多以变形菌门(Proteobacteria)为主要优势类群。牛世全等对河西走廊盐碱土细菌群落结构的研究结果表明,其优势细菌菌群也为变形菌门,另外分布有放线菌门(Actinobacteria)、拟杆菌门Bacteroidetes)、酸杆菌门(Acidobacteria)、浮霉菌门(Planctomy?cetes)、绿弯菌门(Chloroflexi)、芽单胞菌门(Gemmatimonadetes)、厚壁菌门(Firmicutes)和疣微菌门(Verrucomicrobia)。而在新疆阿克苏地区盐碱土细菌研究中,郑贺云等发现其优势菌群为变形菌门的伯克氏菌目(Burkholderiales)、粘球菌目(Myxococcales)、假单胞菌目(Pseudomonadales)、根瘤菌目(Rhizobiales)、海洋螺菌目(Oceanospirillales)和交替单胞菌目(Alteromonadales)。同时还检测到厚壁菌门的芽孢杆菌目(Bacillales)、放线菌门的放线菌目(Actinomycetales)和拟杆菌门的黄杆菌目(Flavobacteriales)。在东部沿海的滨海盐碱土地区,细菌群落则可能以厚壁菌门为优势类群。孙佳杰等研究发现天津滨海盐碱土中的微生物群落以厚壁菌门的乳杆菌属(Lactobacillus)、芽孢杆菌属(Bacillus)为主。而冯伟等研究表明,天津滨海盐碱土优势种群为厚壁菌门的芽孢杆菌属和海洋芽孢杆菌属(Oceanobacil?lus)。
在河套地区的平原盐碱土地区,变形菌门是内蒙古河套灌区3种不同盐碱程度盐碱土的主要细菌类群,且属于耐盐碱菌株。在东北的苏打盐碱土地区,变形菌门和酸杆菌门是主要的优势类群。杜滢鑫等的研究结果表明,酸杆菌门是大庆盐碱土的主要细菌类型。而Peng等研究进一步证实了大庆盐碱土的细菌优势类群为酸杆菌门和变形菌门。而Shi等对安达盐碱土的研究结果显示,变形菌门的嗜盐单胞菌属(Halomonas)、嗜麦芽窄食假单胞菌属(Stenotrophomonas)和嗜碱单胞菌属(Alkalimonas)是主要的细菌类型,同时还包括放线菌门的Nesterenkonia属和刘志恒菌属(Zhihengliuella)、厚壁菌门的芽胞杆菌属以及拟杆菌门的Litoribacter属。
由上述我国不同地域盐碱土细菌群落结构特征的相关报道结果可见,我国盐碱土中分布着大量细菌资源,且不同地域和类型的盐碱土具有不同的优势种群和多样的群落构成,在多数盐碱土地区,变形菌门是优势菌群,而滨海盐碱土地区的优势菌群是厚壁菌门,东北盐碱土地区主要类群有变形菌门和酸杆菌门,这很可能是盐碱土壤理化性质如电导率、pH值、含水量和阴离子组成等作用的结果。因此,进行盐碱土细菌群落结构多样性和相关土壤理化性质的耦合分析,很可能为我国盐碱土细菌群落分布特征机制的解析提供有力的参考。
在盐碱土壤细菌资源中,放线菌是一个重要的类群,其被认为是一类界限微生物,能产生多种生物活性物质,具有很好的应用前景。栖息于盐碱土壤的放线菌,多为嗜盐碱的特殊类群,因而受到了研究者的广泛关注。李海云等通过解析原生盐碱土、次生盐碱土和农田土中的放线菌群落结构特征,发现原生盐碱土的放线菌种群丰富度最高,次生盐碱土次之,农田土最低,这也证明了盐碱土壤中蕴藏着丰富的放线菌资源。李文均等在我国新疆、青海的盐碱土壤样品中,分别分离出8株、32株中度嗜盐放线菌菌株,这些菌株分别属于3个科、5个属中的约10余个种,包括拟诺卡氏菌科(Nocardiopsaceae)的拟诺卡氏菌属(Nocardiopsis)和链单孢菌属(Streptomonospora)、假诺卡氏菌科(Pseudonocardiaceae)的普氏菌属(Prauserella)和糖单孢菌属(Saccharomonospora)、链霉菌科(Streptomycetaceae)的链霉菌属(Streptomyces)及多个新种。
这些放线菌菌株中有的具有产生抗生素、蛋白酶、纤维素酶、淀粉酶和脂肪酶等特性,从这些放线菌中发掘高活性、结构新奇和多样性的化合物,有利于开发新药物。同样针对新疆盐碱土样品,张永光等在新疆阜康盐碱土样品中分离到116株兼性嗜碱放线菌和4株耐碱放线菌,它们分布于8个目13个科22个属,其中有4个为潜在新种,首次在盐碱土中分离到Williamsia属和Verrucosispora属的菌株。可见,盐碱土壤中分布有多种放线菌类群,丰度高且群落结构多样,有大量放线菌新物种资源有待发掘,因此,放线菌资源的挖掘已成为目前我国盐碱土微生物相关的一个热点研究问题。
相关新闻推荐
2、假交替单胞菌WCP15003的生长特性及其对哈维氏弧菌PBVH3311拮抗效果(三)
